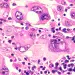

Immunoterapia w skojarzeniu z FMT u pacjentów dotkniętych czerniakiem opornym na leczenie: badanie fazy I
Immunoterapia z wykorzystaniem anty-PD-1 w skojarzeniu z FMT (transplantacją fekalną) nie powoduje większej liczby działań niepożądanych niż sama immunoterapia, a odpowiedź może być lepsza, jak wskazuje badanie fazy I z udziałem 20 pacjentów.
Sekcja dla ogółu społeczeństwa
Znajdź tutaj swoją dedykowaną przestrzeń
en_sources_title
en_sources_text_start en_sources_text_end

O tym artykule
W ciągu ostatnich 10 lat arsenał środków przeciw zaawansowanemu czerniakowi wzbogacił się. Niemniej immunoterapia z użyciem anty-PD-1 nie przynosi korzystnych wyników u jednego pacjenta na dwóch. Dwuskładnikowa terapia skojarzona z wykorzystaniem
(sidenote:
Anti-PD-1
immunoterapia na podstawie inhibitory punktów kontrolnych (checkpoints) układu odpornościowego, likwidująca spowodowane przez guz unieruchomienie systemu rozpoznawania związanego z proteiną PD-1 obecną na powierzchni limfocytów T. Przywrócona zostaje skuteczność działania układu odpornościowego przeciw komórkom guza.
)
i
(sidenote:
Anti-CTLA-4
inhibitor odpornościowych punktów kontrolnych celowany w punkt kontrolny CTLA-4.
)
poprawia odsetek odpowiedzi, ale powoduje zdarzenia niepożądane o podłożu immunologicznym (irAEs). A mikrobiota jelitowa reguluje układ odpornościowy. Może więc skojarzyć immunoterapię anty-PD-1 z transplantacją mikrobioty fekalnej (FMT)? Opcja ta została zbadana w ramach wieloośrodkowego badania fazy I z udziałem
(sidenote:
W wieku od 48 do 90 lat (średnia wieku: 75,5 lat), w tym 12 mężczyzn (60%)
)
chorych na czerniaka nieoperacyjnego lub z przerzutami, nieleczonych uprzednio anty-PD-1. Skorzystali oni z FMT od
(sidenote:
Trzech zdrowych dawców płci męskiej (średnia wieku: 35 lat) dostarczyło stolec wykorzystany, odpowiednio,
u 4, 7 i 9 pacjentów
)
, podanej doustnie (kapsułka), a 7 dni później otrzymali pierwszy cykl immunoterapii
(sidenote:
Niwolumab lub pembrolizumab
)
.
Porównywalny poziom bezpieczeństwa
Głównym kryterium oceny zastosowanym w badaniu było bezpieczeństwo. FMT spowodowała działania niepożądane co najwyżej pierwszego lub drugiego stopnia (biegunka, wzdęcia itp.) u ośmiu pacjentów (40%). Po podaniu anty-PD-1 u 17 pacjentów (85%) wystąpiły działania uboczne, z czego u 5 pacjentów (25%) irAEs trzeciego stopnia (2 przypadki zapalenia stawów, 1 przypadek zmęczenia, 1 przypadek zapalenia płuc, 1 przypadek zapalenia nerek) wymagające tymczasowego wstrzymania leczenia. W porównaniu z terapią anty-PD-1 stosowaną samodzielnie (od 79,5 do 93,2% irAEs w badaniach klinicznych fazy III i od 13,3 do 34,0% irAEs stopnia od trzeciego do piątego) terapia skojarzona obejmująca FMT i anty-PD-1 nie zwiększyła częstotliwości występowania tych zdarzeń.
Potencjalnie lepsza odpowiedź
Pod względem skuteczności poziom obiektywnych odpowiedzi okazał się zadowalający: odpowiedź wykazało 65% uczestników (13 pacjentów), co oznacza poziom odpowiedzi wyższy niż w przypadku monoterapii anty-PD-1 (od 54 do 63% w randomizowanych badaniach fazy III), chociaż małe rozmiary próby i brak grupy kontrolnej (leczonej tylko anty-PD-1) ogranicza interpretację wyników. Osoba dawcy nie miała wpływu na wyniki.
Długofalowa zmiana mikrobioty jelitowej
(sidenote: Na początku, tuż przed zastosowaniem anty-PD-1, a następnie po upływie 1 miesiąca i 3 miesięcy od podania anty-PD-1. ) wykazało, że po FMT zróżnicowanie mikrobioty jelitowej biorców stale rośnie. Jeżeli chodzi o jej skład, to po tygodniu od FMT mikrobiota wszystkich biorców jest bardziej podobna do mikrobioty odpowiednich dawców, ale następnie podobieństwo to zanika u pacjentów, którzy później nie wykażą odpowiedzi na terapię, natomiast nasila się u tych, którzy na leczenie reagują.
Po upływie miesiąca od FMT mikrobiota pacjentów odpowiadających na leczenie wzbogaciła się o (sidenote: Ruminococcus, Eubacterium ramulus i Faecalibacterium ) i stała się uboższa w (sidenote: Clostridium methylpentosum, Enterocloster aldensis, Erysipelatoclostridium ramosum i Enterocloster clostridioformis ) .
Wpływ na limfocyty T?
Badanie wykazało również występujące u pacjentów zmiany metabolitów osocza, w tym wzrost ilości pierwotnych i wtórnych kwasów żółciowych. Po FMT ilość niektórych limfocytów (ICOS+CD8+) we krwi obwodowej rośnie tylko u pacjentów odpowiadających na leczenie.
Ponadto modele mysie leczone przed FMT antybiotykami potwierdzają rolę FMT w podwyższeniu skuteczności anty-PD-1.
Przeczytaj także